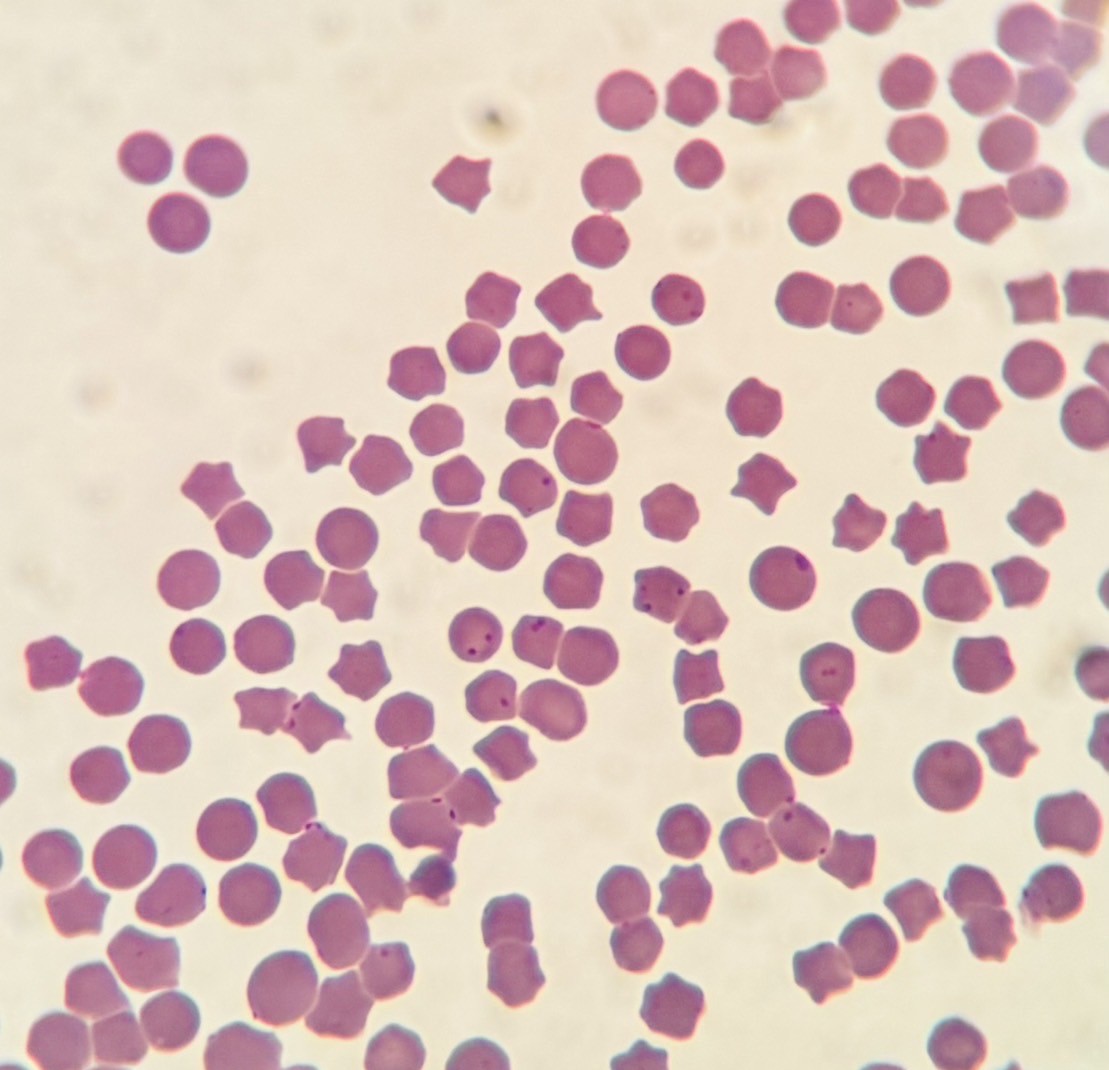
症例紹介：ヘモプラズマ感染症（旧ヘモバルトネラ感染症） あらた動物病院｜横浜市旭区善部町の動物病院｜犬 猫｜土日祝日診療

犬ヘパトゾーン症(いぬヘパトゾーンしょう、英: canine hepatozoonosis)とは、Hepatozoon canis寄生を原因とする寄生虫病。イヌ、コヨーテのほか、日本ではネコやツキノワグマなどにも見られる。
概要
原虫を保有するクリイロコイタマダニの経口摂取により寄生が成立する。多くは不顕性感染であるが、合併症が存在する場合には、発熱、体重減少、嗜眠、貧血、高アルブミン血症、高グロブリン血症などを示す。
診断は血液塗抹標本あるいは骨格筋や皮膚の生検標本にギムザ染色やライト染色を施し虫体を検出する。治療にはイミドカルブ、ドキシサイクリンが有効であり、対症療法として非ステロイド性抗炎症薬が使用されることもある。
参考文献
- 今井壯一ほか編 『最新家畜寄生虫病学』 朝倉書店 2007年 ISBN 4254460279
- 新潟日報平成21年4月27日記事 絶滅懸念ツキノワグマ